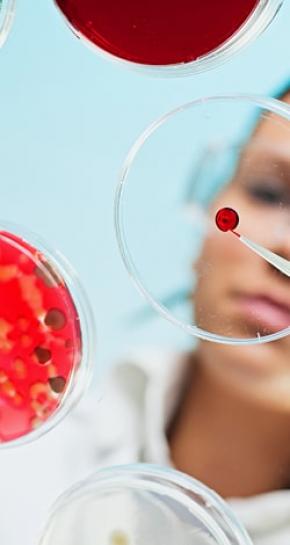

Spaarzaam met profylaxe door opmars schimmelresistentie
Aspergillus, Candida auris en andere schimmels eisen samen jaarlijks meer dodelijke slachtoffers dan malaria. De spaarzaam beschikbare antischimmelmedicijnen zijn niet opgewassen tegen de toenemende resistentie van schimmels. Daarom is het belangrijk om zuinig om te gaan met de behandelingen die er wel zijn en alleen patiënten die een groot risico lopen op een ernstige, inwendige schimmelinfectie, preventief profylaxe te geven.
Wereldwijd komen steeds meer schimmelinfecties voor. Deels komt dat door de medische vooruitgang. We worden met zijn allen steeds ouder en er zijn dus ook meer zwakke ouderen met een verzwakt immuunsysteem, die extra vatbaar zijn.

Ook wordt de wereld ‘kleiner’. We reizen meer en gaan in steden steeds dichterbij op elkaar wonen. Zo krijgen ziekteverwekkers beter de kans om zich te verspreiden. Daardoor krijgen schimmelinfecties steeds vaker vat op mensen die relatief gezond zijn.
Niet alleen het aantal schimmelinfecties groeit. Ook het aantal schimmelresistente infecties neemt snel toe. Dat betekent dat infecties steeds vaker lastig of helemaal niet meer te behandelen zijn met antischimmelmedicatie.
En daarom wordt er in Nederland spaarzaam omgegaan met profylaxe om invasieve schimmelinfecties te voorkomen. Profylaxe wordt alleen gegeven aan bepaalde groepen patiënten die verhoogd risico lopen op een levensbedreigende, inwendige schimmelinfectie.
Longinfectie door resistente schimmel

Een notoir gevaar vormt de schimmel Aspergillus fumigatus. Deze kan met een verkoudheid- of griepvirus mee je longen in liften en daar een levensgevaarlijke infectie veroorzaken. Elk jaar belanden ongeveer zeshonderd mensen in het ziekenhuis met een longontsteking die is veroorzaakt door een schimmelinfectie.
Meer dan tien procent daarvan is lastig of helemaal niet te behandelen door resistentie. Omdat in het begin van de behandeling meestal niet duidelijk is of iemand last heeft van een resistente schimmel, wordt de behandeling vaak gedaan met een combinatie van twee antischimmelmiddelen. Dit verkleint de kans dat de behandeling niet aanslaat.
Er zijn ook andere schimmels, zoals de Candida albicans en de Pneumocystisen Cryptococcus, die ernstige invasieve infecties veroorzaken waarbij we steeds vaker zien dat ze resistent zijn tegen een of andere antischimmelmiddelen.
Candida-schimmels zorgen jaarlijks wereldwijd voor 600.000 invasieve infecties. En alleen in Amerika jaarlijks al voor 35.000 resistente infecties.

De landbouw is medeverantwoordelijk voor de opmars van schimmelresistentie. Omdat daar veel gebruik wordt gemaakt van zogenaamde fungiciden als bestrijdingsmiddelen. Deze bevatten vaak azool, een stof die ook in veel antischimmelmedicijnen zit. Wetenschappers denken dat dit mede heeft gezorgd voor de resistentie onder de Aspergillus fumigatus-schimmels.
Superschimmels
Schimmels kunnen resistent worden tegen verschillende medicijnen tegelijk. Dat heet multidrugresistentie. In 2009 nog werd Candida auris als nieuwe resistente soort ontdekt in Japan. In amper tien jaar tijd heeft deze ‘superschimmel’ zich over de hele wereld verspreid. In 2016 werd hij voor het eerst waargenomen in buurland België. Candida auris kan resistent kan worden tegen alle klinische klassen van antimycoticageneesmiddelen. Daarnaast is Candida auris extreem ziekteverwekkend: een invasieve infectie leidt tot overlijden bij een derde van alle patiënten, mede doordat zij de schimmel makkelijk op elkaar overdragen. Doordat Candida auris al meerdere ziekenhuisbesmettingen heeft veroorzaakt, wordt hij ook wel de eerste ‘ziekenhuisschimmel’ genoemd.
De snelheid waarmee schimmels resistentie ontwikkelen, baart artsen en wetenschappers wereldwijd grote zorgen. Ze vormen een groeiende bedreiging voor de wereldwijde gezondheid. En daarnaast voor onze voedselvoorziening (ook planten kunnen resistente schimmelinfecties oplopen).
De snelheid waarmee schimmels resistentie ontwikkelen, baart artsen en wetenschappers wereldwijd grote zorgen.
Schimmels kunnen snel resistent worden, doordat ze zich snel delen en daarbij kunnen muteren. Bovendien lijkt de celstructuur van schimmels erg op die van andere organismen.
Schimmelcellen bevatten ook een celkern en celorganellen. Daarom is het lastig om middelen te vinden die schimmels doden, maar die niet schadelijk zijn voor de celstructuren van mensen, dieren en planten.
Minder media-aandacht voor oprukkende schimmelresistentie
Over de wereldwijde crisis op het gebied van antibioticaresistentie en de opmars van resistente bacteriën zoals de beruchte ziekenhuisbacterie meticillineresistente Staphylococcus aureus (MRSA) wordt veel geschreven en gepubliceerd in wetenschappelijke tijdschriften.
Maar er is veel minder media-aandacht voor de oprukkende schimmelresistentie. En ook vanuit de onderzoekswereld blijft de aandacht uit.
In het Global Report on Antimicrobial Resistance Surveillance van de Wereldgezondheidsorganisatie (WHO) wordt uitgebreid aandacht besteed aan de opmars van resistente bacteriën. Resistente schimmels worden daarentegen slechts terloops genoemd.
Tekort aan onderzoek
Antibioticaresistentie is duidelijk een speerpunt voor de WHO, schimmelresistentie is dat niet. Het gebrek aan onderzoek, geld, en aandacht vertaalt zich in gebrekkige wereldwijde monitoring van schimmelresistentie. En het leidt ook tot een tekort aan onderzoek naar schimmelinfecties en nieuwe antischimmelmiddelen.
Toch gloort wel een beetje licht aan de horizon. Er zijn geneesmiddelenbedrijven, waaronder Pfizer, die onderzoek doen naar schimmelinfecties en nieuwe behandelingen om ze te genezen.
Een ander lichtpuntje is dezelfde medische vooruitgang die we al eerder noemden. Nieuwe medische behandelingen doen een steeds minder grote aanslag op het afweersysteem van mensen met kanker of andere ziekten. Ook dat verkleint het risico op een invasieve schimmelinfectie.
Bronnen
https://www.eoswetenschap.eu/gezondheid/levensbedreigende-schimmelinfecties-rukken-op
https://www.nemokennislink.nl/publicaties/antischimmelmiddel-resistentie-op-komst/
https://www.skion.nl/workspace/uploads/2019-Antischimmel-beleid-Final.pdf
https://www.ntvg.nl/artikelen/behandeling-en-profylaxe-van-gegeneraliseerde-mycosen/volledig
Enzler, M. J., Berbari, E., & Osmon, D. R. (2011, July). Antimicrobial prophylaxis in adults. In Mayo Clinic Proceedings (Vol. 86, No. 7, pp. 686-701). Elsevier.
https://eenvandaag.avrotros.nl/item/artsen-luiden-de-noodklok-over-dodelijke-schimmelinfectie/
https://www.who.int/antimicrobial-resistance/publications/surveillancereport/en/
https://www.cdc.gov/drugresistance/pdf/threats-report/2019-ar-threats-report-508.pdf
https://www.sciencedirect.com/science/article/pii/S0195670117305133




